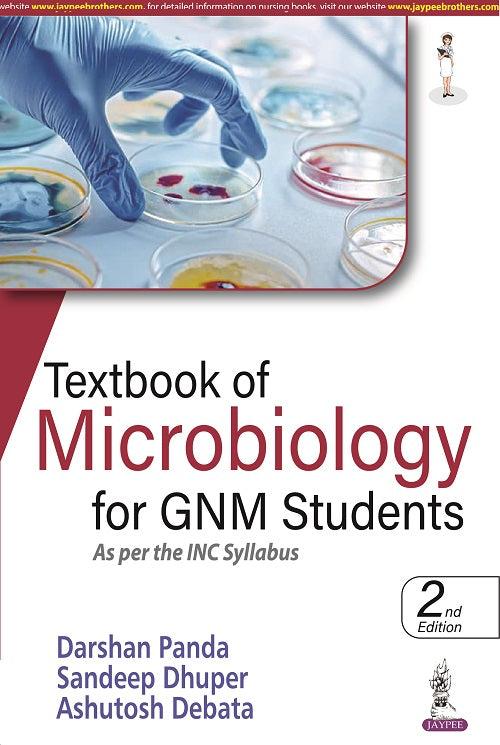

TEXTBOOK OF MICROBIOLOGY FOR GNM STUDENTS AS PER THE INC SYLLABUS
423.00
650.00
Category:
Medical Science ,
Microbiology
Author:
DARSHAN PANDA
Edition:
2/E R.P.
Language:
English
Publish Year:
2024
Publisher:
JAYPEE
Pages:
444
Type:
ISBN:
9789354659539